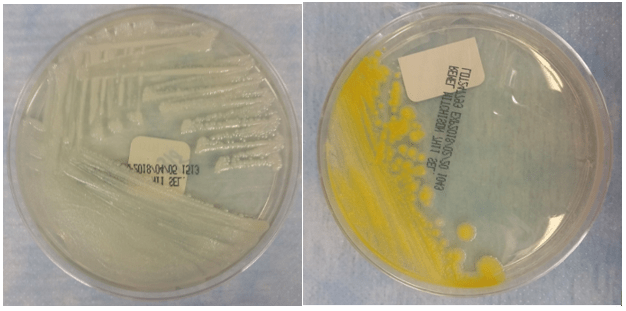
mycokans3

Case History
62 year old male from Louisiana with a medical history of COPD presents with fever, productive cough, weight loss, and a red nodule on the left hand. Chest x-ray shows interstitial and lobar infiltrates. Patient reports no recent travel history. Mycobacterial culture of the sputum is positive for an organism. MALDI-ToF of the sputum culture confirms the result.
Lab Identification

Mycobacterium kansasii grows on 7H11 media and Lowenstein-Jensen (LJ) slants. The colonies appear smooth or rough and unpigmented when isolated in the dark. Upon exposure to light, colonies turn bright lemon yellow due to enhanced b-carotene production, which makes M. kansasii a photochromogen. M. kansasii stains positive with acid-fast stains. On Kinyoun stain, it shows long bacilli with a banded, ladder like pattern. M. kansasii is positive for nitrate reduction, catalase, urease, and tween hydrolysis. It is negative for niacin and pyrazinamindase. The identification of M. kansasii is confirmed by MALDI or DNA probe of an isolate.
Discussion
Mycobacterium kansasii is a slow growing photochromogen, an organism that grows unpigmented colonies in the dark but produces a bright lemon yellow pigment upon exposed to light3. It is also an acid-fast positive long bacillus that causes TB-like chronic pneumonia, which is the second most common non-TB mycobacterial infection after MAC in the AIDS population. There are five genotypes of Mycobacterium kansasii. Genotypes I and II infect humans, with I being the most prevalent. Because environmental sources of M. kansasii are rarely identified, isolation of M. kansasii from a culture is never considered a contaminant.
M. kansasii is usually found in the tap water in cities endemic for the infection. In the U.S., it is most prevalent in the central and southern states including Louisiana, Illinois, Texas, and Florida1. Internationally, it is most prevalent in Israel, Korea, France, Japan, Portugal, with the highest incidence in England, Wales, and among South American gold miners.
The majority of patients with M. kansasii infection have an underlying pulmonary disease such as COPD, bronchiectasis, or TB infection3. The clinical manifestation of M. kansasii infection includes a primarily unilateral cavitary infiltrate in the lungs without pleural effusions. Patients are generally older compared with those infected with TB. They present with productive cough, weight loss, fever, night sweats, and dyspnea. Symptoms are usually less severe but more chronic compared with those of TB pneumonia. M. kansasii can also present as cutaneous lesions similar to sporothrichosis. Lesions include nodules, pustules, red plaques, and ulcers1.
M. kansasii infection is diagnosed by chest X-ray or chest CT, positive respiratory culture, and clinical exclusion of other diagnoses2. The criteria for a positive culture include either two consecutive positive sputum cultures, one positive culture from bronchoscopy specimens, or one positive culture with compatible clinical symptoms2. The treatment of M. kansasii infection depends on the resistance of the organism to rifampin. Rifampin-sensitive organisms are treated with at least three drugs including rifampin, ethambutol, isoniazid, and pyridoxine1. Rifampin-resistant organisms are treated with three drugs including clarithromycin or azithromycin, moxifloxacin, ethambutol, sulfamethoxazole, or streptomycin1. Due to drug interaction, rifampin is contra-indicated among HIV patients taking protease inhibitors and nonnucleoside reverse transcriptase inhibitors. Because rifampin increases the metabolism of these HIV medications, it can lead to HIV drug resistance among these patients.
References
- Akram SM, Bhimji SS. Mycobacterium Kansasii. StatPearls. 2018. https://www.ncbi.nlm.nih.gov/books/NBK430906/
- Johnston JC, Chiang L, Elwood K. Mycobacterium Microbiol Spectrum. 2017;5(1):TNMI7-0011-2016. doi:10.1128/microbiolspec.TNMI7-0011-2016.
- Meraz A, Raheem S. Pulmonary Mycobacterium Kansasii Infection –A Tale of a Right Upper Lobe Cavitary Lesion [abstract]. Journal of Hospital Medicine. 2015; 10 (suppl 2). https://www.shmabstracts.com/abstract/pulmonary-mycobacterium-kansasii-infection-a-tale-of-a-right-upper-lobe-cavitary-lesion/. Accessed March 12, 2018.
-Ting Chen, MD is a 1st year anatomic and clinical pathology resident at the University of Vermont Medical Center.

-Christi Wojewoda, MD, is the Director of Clinical Microbiology at the University of Vermont Medical Center and an Associate Professor at the University of Vermont.
Lowenstein Jensen medium is recommended for the isolation and cultivation of Mycobacterium species. https://labweeks.com/lowenstein-jensen-medium/